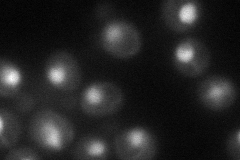
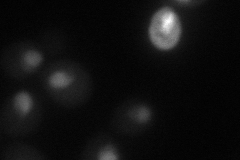
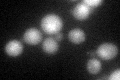

View description
Protein whose overexpression suppresses the growth defect of mutants lacking protein kinase A activity; involved in cAMP-mediated signaling; localized to the nucleus; similar to the mouse testis-specific protein PBS13
Localization:
Intensity:
Fold change:
Significance:
-
C’ GFP library in SD

nucleus30.79 -
N' NOP1pr-GFP in SD
nucleus,nucleolus65.423 -
N' TEF2pr-mCherry in SD
nucleus37.7436 -
N' NATIVEpr-GFP in SD

nucleus36.2351 -
N' TEF2pr-VC and Cyto-VN in SD

#N/A0 -
C’ GFP library in SD+DTT
nucleus26.570.86No -
C’ GFP library in SD+H2O2

nucleus33.391.08No -
C’ GFP library in Starvation Media

nucleus28.910.93No -
C’ GFP library on the background of Pup2-DaMP

nucleus -
C’ GFP library on the background of CCT mutant

nucleus38.09611.23704No
